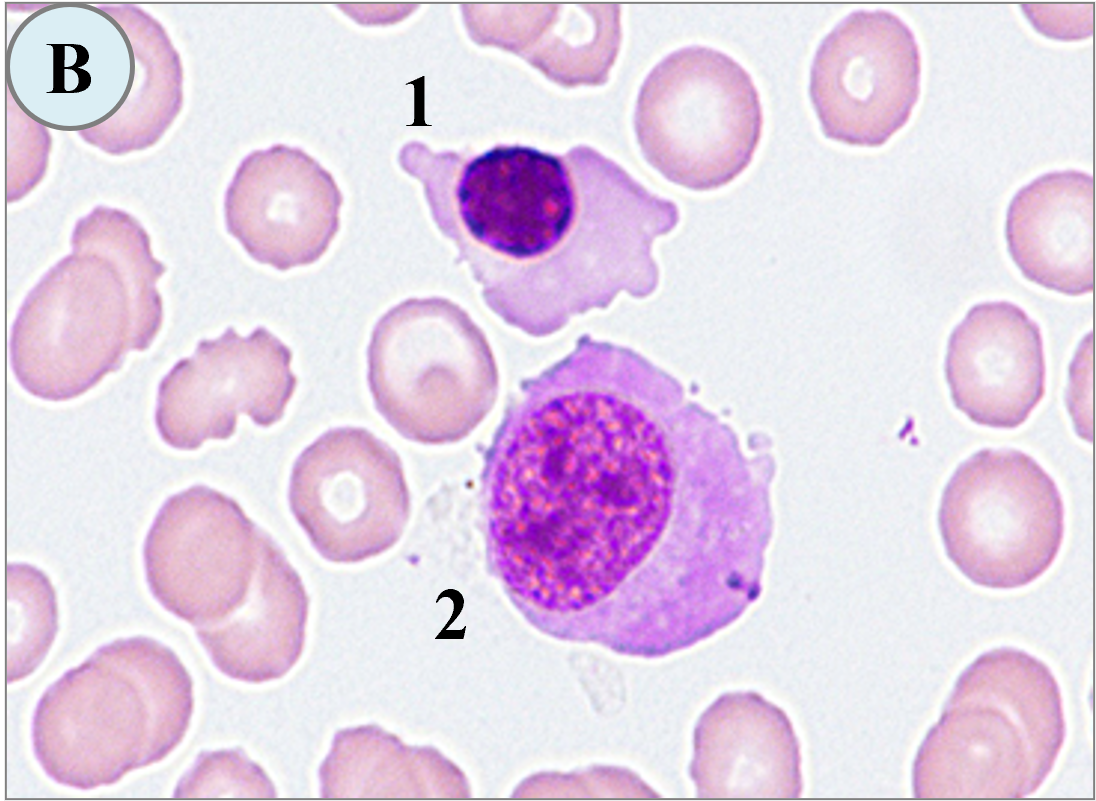

茶碗蒸しの歴史は平安時代に遡ります。もともと貴族や武士の間で食べられていた高級料理の一つとされていました。
起源は、1689年頃(江戸時代)、長崎で卓袱(しっぽく)料理の一品として登場したことが始まりとされます。イギリス発祥の蒸し菓子(プディング)の製法が中国に伝わり、それが料理として長崎に伝わったのがルーツという説があります。やがて庶民の間でも普及し、現在のように家庭料理として楽しまれるようになったと考えられています。ちなみに、卓袱料理とは中国や西欧の料理と日本料理が融合した長崎の郷土料理で、朱塗りの円卓を囲み、大皿に盛られた料理を小皿に取り分けて食するスタイルです。
その歴史を継承し、1866年創業の長崎市万屋町にある「吉宗(よっそう)」は、茶わん蒸し、蒸寿し専門店として今もなお健在です。また、熊本市花畑町にある茶碗蒸し本舗「稲穂(いなほ)」は、30種類もの茶碗蒸しを楽しめ、美味しさの決め手はこだわりの出し汁にあるといわれます。
卵と出し汁のシンプル料理は時代を超えて、今や日本独自の様々なバリエーションが生まれ、具材や出汁の種類、調理法などが地域ごとに異なり進化してきました。近年では、和食だけでなく、洋風のアレンジを加えた茶碗蒸しも登場し、世界中で親しまれています。また、ヘルシー志向が高まり、低カロリーの食材やダイエット向けのアレンジが人気です。例えば、卵白だけを使用したり、ヘルシーな鶏肉や野菜を多く加えることで、栄養バランスを考えた茶碗蒸しが多くのレストランで提供されています。
まだまだ猛暑は続いておりますが、気分だけでも秋を先取りして、「茶わん蒸し」を味わっては如何でしょうか。

2025年8月号の問題. 下記のご質問をいただきましたがどのようにお答えしますか。
| 【Q1】 | 神経芽腫など腫瘍細胞が孤発性に出現した場合、芽球との鑑別方法はありますか。 | |
| 【助言1】 | 神経芽腫の腫瘍細胞は非上皮性結合を呈し孤発性にみられることが多いのですが、特徴とされるロゼット様形成(平面的)の出現が所見になることもありますので周囲を観察します。細胞形態はクロマチンが粗網状、濃染性の核影が多くみられることも特徴です。一方、芽球(pre B-ALL)は、N/Cが高く、クロマチンは粗剛ながらも緻密で、核影は淡染性が多いようです。なかでも小児のpre B-ALLの場合はPAS染色に点状~塊状陽性の確率が高くなります。しかし、確定診断には、神経芽腫は画像診断、尿中VMA・HVAや免疫染色などが、ALLでは免疫表現型(B/Tの鑑別)が有効になります。 | |
| 【Q2】 | 細胞分類で、前骨髄球か骨髄球かを鑑別するのに悩むことがあります。同様に、前赤芽球か塩基好性赤芽球か悩むこともあります。 | |
| 【助言2】 | お悩みの細胞は、多くは分裂能を有する細胞で、移行形(中間型)と考えます。その場合、成熟型の所見を少しでも示していれば、成熟の方向に判定することをお薦めします。顆粒球では、前骨髄球、骨髄球の顆粒に二次的変化(細胞質の脱顆粒や豊富な顆粒の出現)が起こりますので核所見を重視して判定しております。一方、前赤芽球と好塩基性赤芽球については、前者は細胞が大きく、クロマチンは細顆粒状、核小体を有し、細胞質は好塩基性で舌状(コブ状)の突起が特徴です。後者は細胞は小さくなり、クロマチンは顆粒状から粗剛、細胞質の好塩基性が強いことが特徴です。 | |

2025年9月号の問題. 下記のご質問をいただきましたがどのようにお答えしますか。
| 【Q1】 | 大リンパ球と単球の見分け方についての質問です。大きくて細胞質の青味が強めのリンパ球と青味が少ないリンパ球、また単球の鑑別に悩んでおります。鑑別の方法を教えてください。 |
|
| 【Q2】 | 血液室に配属され、末梢血液像にみられるリンパ球と有核赤血球の鑑別がうまくいきません。何かアドバイスをいただけますか。 |
|

形態マガジン号キャプテン 阿南 建一

「細胞同定」については、骨髄像の鑑別細胞を提示しました。画像は高倍率(1,000倍)で提示しています。細胞の大きさは赤血球の大きさを対照に判定してください。
「ワンポイントアドバイス」は、神経芽腫の腫瘍細胞とALLのリンパ芽球との鑑別、顆粒球や赤芽球系の分化段階に出現する移行形(中間型)について解説します。
問題1
BM-MG.1000

BM-MG.1000

BM-MG.1000

BM-MG.1000

問題
骨髄像の細胞同定を行ってください。
【解説】

A-1. 直径22µm大、N/Cは高く(約70%)核は類円形でクロマチンは網状繊細で大きな核小体を認め、細胞質は淡青色で顆粒を認めず骨髄芽球を考えますが、大型で明瞭な核小体を有することからタンパク合成の旺盛さが推測され腫瘍性の骨髄芽球にしました。
A-2. 直径8μm大、N/C比が高くクロマチンの粗剛さからリンパ球を考えますが裸核細胞かも知れません。
B-1. 直径15μm大、細胞質は小型なりに豊富で紫紅色、核は円形でクロマチンの凝集がみられることから成熟乖離を考え正染性巨赤芽球にしました。正常の正染性赤芽球のクロマチンは濃染性を呈します。
B-2. 直径18μm大、細胞質は豊富で青紫色(多染性)、核は類円形でクロマチンは粗網状(スポンジ様)であり、核と細胞質の成熟にズレ(核の遅延)がみられることから多染性巨赤芽球にしました。

C-1. 20μm大、細胞質はやや豊富で青紫色を呈し核周に明庭部を認め、核は円形で粗網状(スポンジ様)で成熟乖離とみなし多染性巨赤芽球にしました。
C-2. 直径11μm大、細胞質は核に準じた広さで淡青紫色、核は円形でクロマチンは淡青紫色のことから多染性赤芽球にしました。
C-3. 直径27μm大、核形不整が顕著でクロマチンは繊細傾向、細胞質は薄青色で微細顆粒を有することから大型の単球にしました。

C-1. 直径12µm大、核は類円形でクロマチンは虎斑状にもみえ、細胞質は青色で核周明庭や空胞を有することから形質細胞にしました。
C-2. 直径28μm大、細胞質は豊富で辺縁は不明瞭で太めの顆粒を有し、核は網状核であることから細網細胞にしました。
C-3. 直径14μm大、N/C比は高く(約90%)核は円形でクロマチンは網状繊細、細胞質は淡青色で顆粒は不明のことから骨髄芽球にしました。A-1.の腫瘍性の骨髄芽球に比べ小型であることから正常型と考えます。
これから先のページでは、医療関係者の方々を対象に医療機器・体外診断薬等の製品に関する情報を提供しております。当社製品を適正に使用していただくことを目的としており、一部の情報では専門的な用語を使用しております。
一般の方への情報提供を目的としたものではありませんので、ご了承ください。
医療関係者の方は、次のページへお進みください。
(お手数ですが、「進む」ボタンのクリックをお願いします)